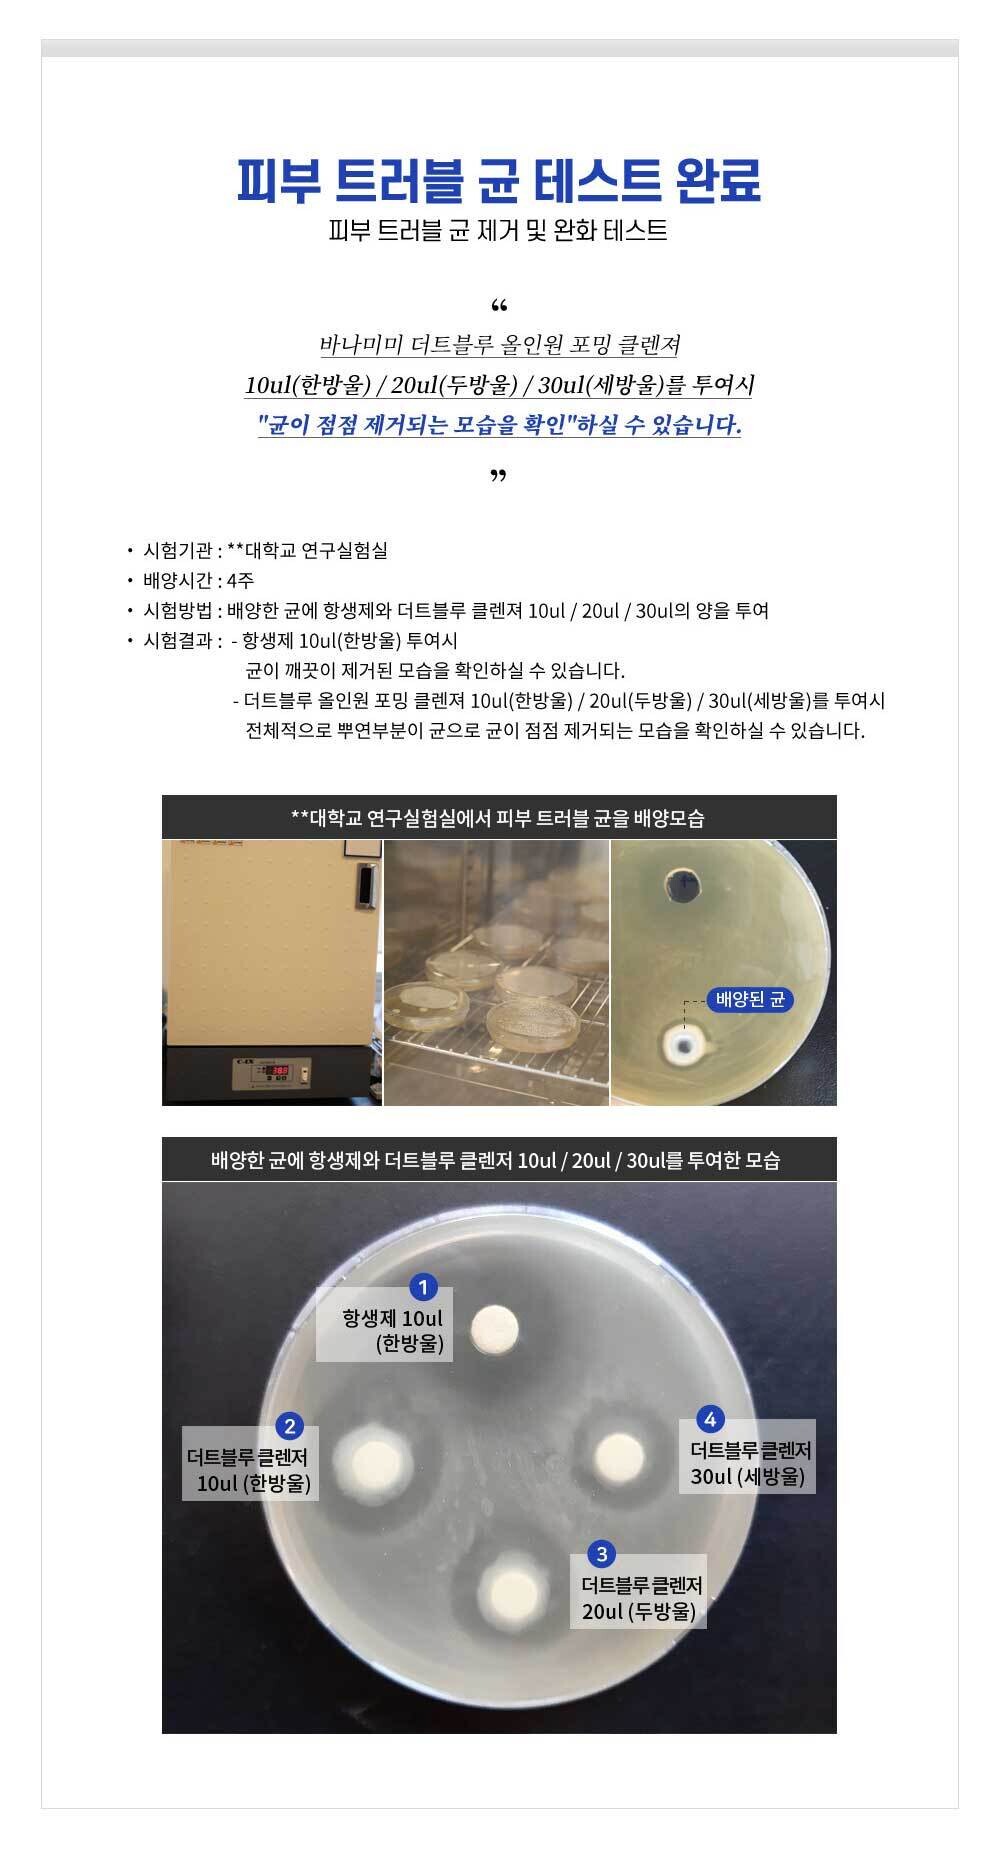

더트블루 남성 기능성 화장품 세트 (스킨+로션+에센스+폼클렌저)
16,900원
28,900원
배송비
-
옵션선택
선택하세요.
선택하세요.
더스크(에센스500ml)
더스크(에센스1000ml)
(+8,000원)
데이 로션(500ml)
(+4,000원)
데이 로션(1000ml)
(+12,000원)
폼 클렌저(500ml)
(+10,000원)
주문 수량
0개
총 상품 금액
0원

더트블루 남성 기능성 화장품 세트 (스킨+로션+에센스+폼클렌저)
16,900원
28,900원
옵션선택
선택하세요.
선택하세요.
더스크(에센스500ml)
더스크(에센스1000ml)
(+8,000원)
데이 로션(500ml)
(+4,000원)
데이 로션(1000ml)
(+12,000원)
폼 클렌저(500ml)
(+10,000원)
주문 수량
0개
총 상품 금액
0원
